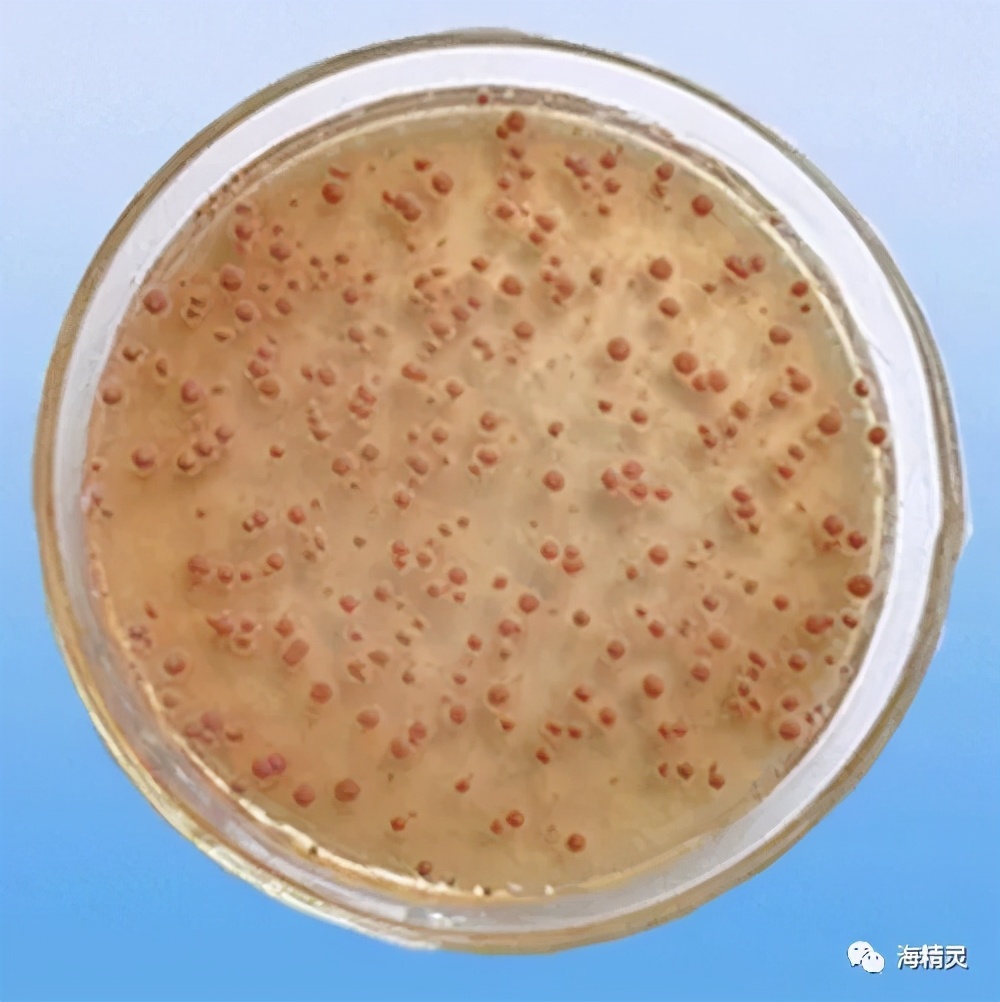
硝化细菌深入研究的九大误区,硝化细菌到底如何选择

十几年前我们养鱼,我们还不知道水体里有啥,而现在养鱼,人人都是化学家和物理学家了。特别是硝化细菌这个词对众鱼友来说已经不再陌生。
九十年代中后期,硝化细菌产品华丽登场,如今不论是玩海水还是玩淡水,没人会忽视硝化细菌的问题。可是听了这么多年,用了这么多年,到底硝化细菌产品有没有起到我们想象的作用?添加与不添加的差别究竟有多大?可能鱼友们都没有静下心来详细研究过。

硝化细菌是一种好氧性细菌,其实是由相亲相爱的硝化菌和亚硝化菌哥俩组成的。它们生活在有氧的水中或砂层中,在氮循环水质净化过程中扮演着很重要的角色。硝化细菌平时是肉眼不可见的,只有用革兰氏染液给它们洗过澡之后才能看到红色的它们。
氮循环的过程
在我们的海缸中,氮元素是无处不在的,藻类、鱼儿、饲料、植物、生物排泄物中都有它的身影,氮也是构成蛋白质的必要元素。那么死去的生物/植物/藻类、没吃完的饲料和排泄物中的氮都去哪里了呢?其实它们是被一些称为腐生菌的家伙给分解了,有机的氮变成了无机的氨。而氨NH3对于鱼儿们来说是有剧毒的,它能使鱼类血液中蛋白质变性而失去生理功能,只要水体中氨的浓度超过0.2ppm时就会造成鱼类的急性暴毙。

毒害鱼儿的几个主要因素分别是氨NH3和亚硝酸盐NO2等,那既然这么毒,为何鱼友们家的鱼儿都还活得好好的呢?哈哈,就是因为有了我们今天文章的主角硝化细菌的功劳。首先由弟弟亚硝酸菌负责把氨氧化成亚硝酸盐,再由哥哥硝化菌将亚硝酸盐NO2氧化成微毒的硝酸盐NO3。
硝酸盐对鱼类来说是相对无害的,除非达到非常高的水平。硝酸盐会以多种方式离开我们的海缸。我们可以通过换水来摆脱它。或者一些藻类,甚至一些珊瑚可以把它当作食物。

自营性细菌
硝化细菌是属于自给自足的一种细菌,科学家称其为自营性细菌,它们利用最简单的无机物如二氧化碳为碳源来构成身体,而提供其日常的能量源泉则来源于氧化NH3和NO2的过程中所释放出来的能量。相对应的如腐生细菌则被称为异养性细菌。
硝化细菌的住所
虽然水中也有游离的硝化菌存在,但硝化菌必须在附着物表面才能很好的工作,我们使用多孔的礁石就是为了给细菌的生长提供尽可能多的温床。它们一旦发现有什么固体物质例如我们缸里的礁石时,就会立即分泌一种黏性物质,牢牢地将自己粘到附着物上,就这样一层叠一层的,直到形成被鱼友们称为生物膜的薄膜。

硝化细菌的繁殖
硝化细菌需要10-20多小时才能繁殖一代(而1个异养性细菌在不到一天的时间内就可以分裂成10亿个),所以一般我们开缸建立硝化系统则需要4-5周以上的时间。特别是在食物缺乏和环境恶劣的情况下硝化细菌还会自主进入最长可达数年的休眠期,而市面上的硝化细菌产品就是利用了它们的这一特点,像是来自法国的科迪硝化细菌就采用了安瓶包装,保质期可达五年之久。

开缸综合征
日常我们新开缸的时候可能会遇到一种被称为“开缸综合征”的状况,表现为在一个月内鱼儿们会不明不白地全部死去。其实主要是由于在开缸初期生物过滤系统还未成熟,有些鱼友就迫不及待地放入心爱的鱼类或生物。鱼类的排泄物被异养菌分解为氨等有害物,而异养菌又繁殖得太快,越来越多的氨被分解出来,逐渐超出了生物的忍受极限,于是就……
正确的做法应该是,在最初期,依照指示加入硝化细菌到已预设好而未成熟的生物过滤系统内。然后挑选一些体格强健,对水质要求较低的鱼类入缸(如雀鲷类)。
我们日常的一些行为也会对硝化细菌的健康不利,比如一些治疗鱼病的鱼药、硫酸铜、高锰酸钾等。所以在治疗鱼病后一定要注意,如果硝化细菌统统阵亡了,即使是老缸也有可能发生开缸综合征,一定要注意及时补充。

好氧、厌光性
硝化细菌对于氧气有一种发自骨子里的热爱,在低氧环境下无法有效的正常工作。可能还有人不知道它们对于光线有多么的惧怕,特别是弟弟亚硝酸菌对于紫外线格外的敏感。所以在建立硝化系统的过程中一定不能使用紫外消毒灯,另外也要尽量创造一个较暗的工作环境。

什么时候使用硝化细菌?
硝化细菌不仅仅在开缸的时候添加,在日常的水质维护中,也应定期添加。因为海缸水体有限,无法像自然海洋那样,可以通过强大的生物系统内部自我调节并保持稳定。海缸的硝化系统比较脆弱,很可能因为一些微小变化造成巨大的影响。
如果有机物的代谢出现波动,例如偶尔喂食量变大,或者突然增加了几条鱼,都会造成水中氨、亚硝酸盐等元素的波动,如果这个波动超出了硝化系统的承受能力,就会发生水质急剧恶化,水中有毒物质浓度急剧上升,进而细菌大量死亡,这进一步削弱了硝化系统的能力,如此恶性循环造成硝化系统崩溃。

不要把硝化细菌看成什么神奇的东西或是觉得是药不敢用,硝化细菌没那么神奇也不是“药”,因为它不是化学药品,是生物制剂,所以没有任何毒性,多加了也不会积累有毒物质或造成某种化学物质超标。鱼友们应该把它作为一种日常水质维护剂来看待和使用。

硝化细菌的挑选
有的鱼友可能会说看到很多硝化细菌产品宣传吹得神乎其神,可以迅速分解粪便、有机物等等,好像加了硝化菌,缸里的一切污物都可以扫光光。事实确实如此,经过这么多年的研发,现在很多市售的硝化细菌产品都是属于复合菌制剂,考虑到了鱼友们日常实际使用场景,不单单只靠硝化细菌处理氨和亚硝酸盐等,还会添加其他的菌种帮助解决其他问题。

比如来自法国的科迪硝化细菌就是由产酶异养硝化细菌、产酶芽孢杆菌、放线菌、乳酸菌、好氧反硝化菌等多种菌种复合制成,面对排泄物、腐烂植物、食物残渣等污物大军处理起来得心应手。

另外如果出现了缸内物理浑浊,除了适当地添加硝化细菌之外,还应该加强过滤循环,*管双**齐下才能更好地解决问题。